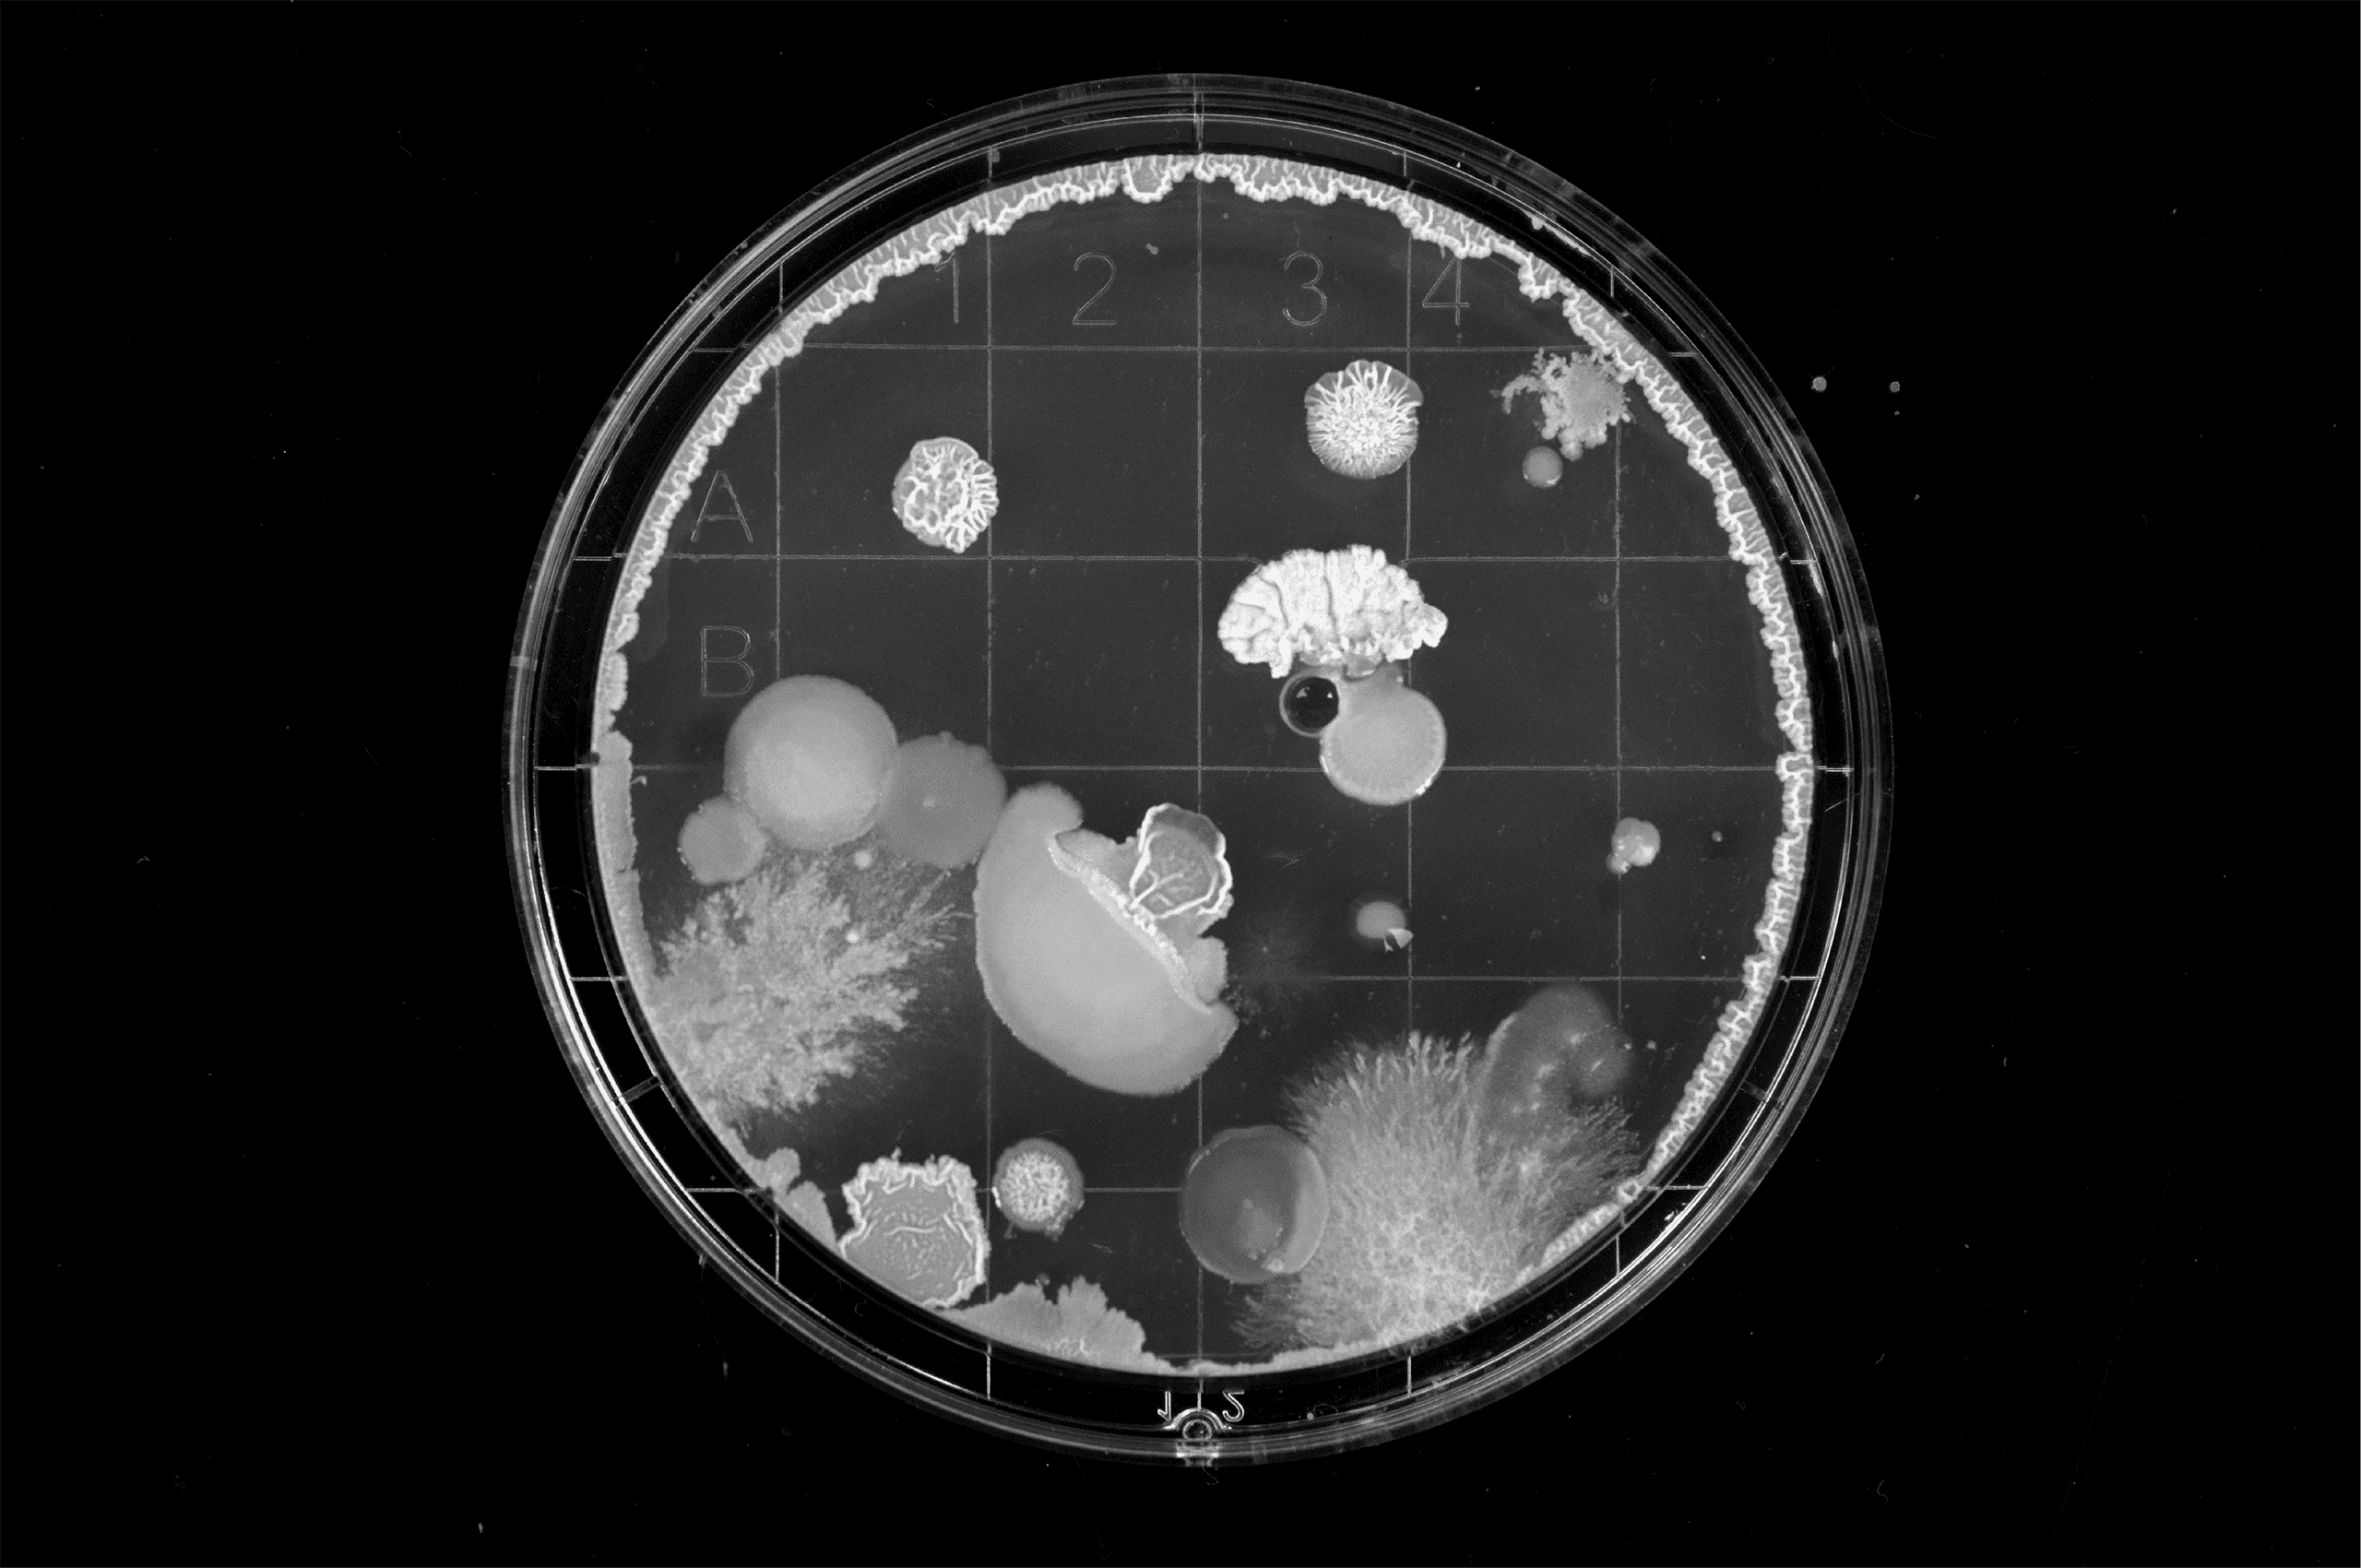

Caladan
A brand for a revolutionary bioreactor company that epitomizes exploration, innovation, and precision.
A brand for a revolutionary bioreactor company that epitomizes exploration, innovation, and precision.

Caladan specializes in manufacturing affordable benchtop bioreactors, providing researchers with novel hardware designed to increase throughput and data acquisition from each experiment significantly. Their bioreactors are equipped with fully integrated software, allowing seamless control and monitoring of the entire Caladan system. This software suite encompasses experiment design, live experiment viewing, and comprehensive data analysis, all consolidated into a single, user-friendly platform. By streamlining these processes, Caladan enables more efficient and effective experimentation, empowering scientists to achieve more insightful results quickly.
Caladan was born from the deep understanding and experience of its founders, Rob Jauquet and Mike Kobida, who identified a significant gap in the bioreactor market after years of working in the technology sector. Their aim was precise: to provide affordable, high-quality benchtop bioreactors and make advanced bioreactor technology accessible to more researchers.
Before emerging from stealth mode, Rob and Mike approached Mast to develop an identity for their revolutionary company. Together, they created a brand that embodies exploration, innovation, and precision, fusing futuristic and organic elements with modernism—resulting in a timeless visual identity that reflects Caladan’s commitment to advanced biotechnology.




When developing the symbol, we drew inspiration from the intricate process of cell division, creating a link to the product and the possibilities of growth and innovation for the company. This approach established a solid connection to the name within the market. As cells divide and multiply to create new life, Caladan strives to foster growth and innovation. By creating a connection to the process and establishing an “ah-ha” moment with the hidden “C,” we can captivate the audience, ensuring it is unforgettable.

Expanding on the forms that built the symbol, we crafted a comprehensive suite of shapes to be utilized across all brand elements, from graphics to frames. These cell-division-inspired shapes ensure a consistent and impactful visual language. The dynamic imagery of cell division is a powerful symbol of Caladan’s unwavering commitment to evolution, adaptation, and the continual renewal of ideas.



This imagery encapsulates the essence of progress, representing the company’s relentless pursuit of innovation and its limitless potential for growth and advancement. Just as cells divide and multiply to create new life, Caladan seeks to multiply its impact, pushing boundaries and driving positive change in biotechnology.






In addition to graphic frames and cell-division imagery, we crafted a suite of illustrations to be seamlessly integrated throughout the brand’s visual identity. These illustrations serve a dual purpose: they help elucidate complex topics that are challenging to explain through text alone, and they provide a fresh, engaging perspective on various hardware and software elements.

By leveraging these illustrations, Caladan can effectively communicate its innovative concepts and cutting-edge technology to a wide audience, making its brand both accessible and visually compelling.





By simplifying the cell division imagery into solid shapes, we significantly expanded the graphic suite, adding a layer of versatility and boldness to the brand’s visual identity. These simplified shapes serve as a bold expression of the brand, offering a contemporary and dynamic visual language that can be applied across various design elements. From serving as bounding boxes for text to acting as frames for photographs, these shapes provide a cohesive and distinctive look that enhances the overall brand experience.




We collaborated closely with the Caladan team to develop a website that not only captivated viewers but also immersed them in Caladan’s world—one of evolution, adaptation, and the perpetual renewal of ideas.
